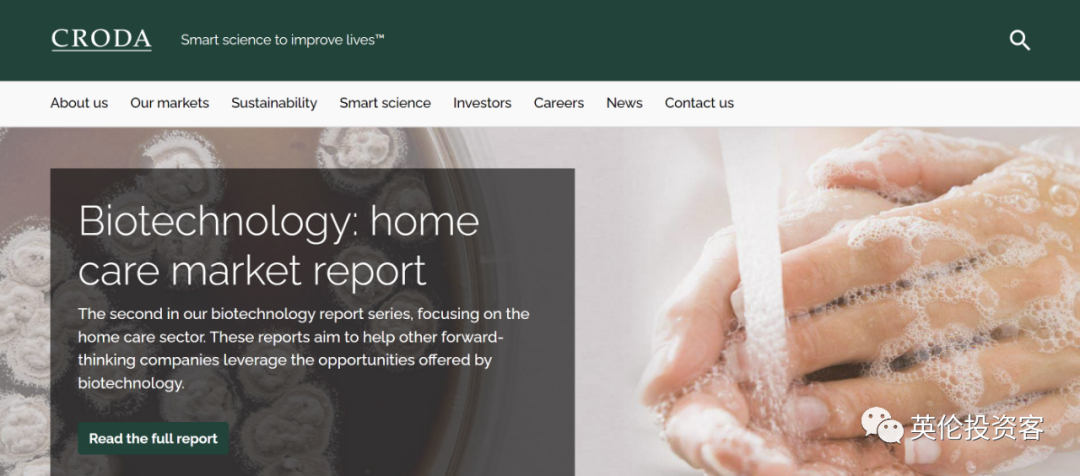

英国股市大涨创历史新高!哪些股票值得买?
一直表现平平的英国股市正在异军突起。
本周三(2023年2月15日),英国基准股指富时100(FTSE 100)收盘上涨0.55%创新高,盘中触及8,003.7点,历史上首次突破8000点,超过了2018年5月22日创下的7903.50点。
除了节节高升的富时100指数,关注英国国内市场的富时250指数(FTSE 250)今年也上涨了5%,易捷航空(EasyJet)、快餐连锁店Greggs、英国独立电视台(ITV)和玛莎百货(M&S)等公司均有较好表现。
相比于全球其他股指,英国股指在之前几年一直表现平平。但随着经济预期的变化和英国股指的走高,越来越多的股民开始转向英国股市。
那么,英国股指究竟为何上涨?对投资者有哪些利好?哪些股票值得投资者们关注?
下面,我们就来分别看看。
富时100指数为何能涨?
如果说在今年全球股市上涨的情况下,富时100指数上涨不算稀奇,那么在去年全球股市暴跌近20%之际,富时100指数还能成功避免下跌,就值得一说了。
数据显示,富时100指数在2022年上涨0.9%,为投资者带来了4.6%的总回报,是全球所有大型股指中唯一一个为投资者带来正回报的指数。
分析人士指出,英国股市曾过度依赖石油和矿业集团、银行、保险公司、公用事业和消费必需品,缺乏与苹果、亚马逊和谷歌等公司竞争的高增长科技股,遭到投资者忽视。
但鉴于通胀和加息正在挤压上述科技公司的估值,投资者开始转向价值型股票(如银行、零售商和能源公司),英国股市过去的缺点变成了优点。
富时100指数以石油公司和银行为主,例如英国石油(BP)、壳牌石油(Shell)、汇丰银行等企业。
此外,富时100指数还有药企阿斯利康(AstraZeneca)和联合利华等跨国公司,约82%的税后利润来自海外,通常从英镑走软中受益(英镑去年下跌了约10%),因此帮助英国股市避开了2022年全球股市暴跌,并克服了英国国内经济衰退的拖累。
据彭博社分析,富时100指数本周突破8000大关,也与壳牌和英美烟草公司等权重股上涨,以及通胀数据公布后英镑下跌有密切关系。
2023年迄今为止,富时100指数已经上涨了6.65%,好于2022年全年0.9%的增幅。
然而,拉长时间周期来看,英国股市的表现依然平平。富时100指数较1999年互联网时代的高点仅上涨14%,同期美国标普500指数的市值已上涨逾2.5倍。
过去5年里,富时100指数的回报率仅为23.8%,如果将股息计算在内,相当于每年上涨了4.37%。同一时期,以英镑计算的MSCI全球指数上涨了60.63%,包括股息在内相当于每年上涨9.95%。
对投资者来说,英国股市有哪些优势?
简单来说,最大优势就是便宜。
虽然英国股市的富时100指数不断攀升,但由于它的市盈率(Price-to-earnings,富时100指数为11,而美国标准普尔500指数为19.5)在全球范围内较低,对投资者来说依然非常友好。
这里科普一下市盈率这个概念,它是衡量一家公司偿还市值所需时间的粗略指标,计算公式为——市盈率=普通股每股市场价格/普通股每年每股盈利。
通常来说,市盈率低一般说明股价被低估;市盈率高则说明购买时应谨慎。不过这一规律也不一定完全对,毕竟高市盈率股票多为热门股,低市盈率股票则多为冷门股。
英国投资管理公司Kingswood认为,富时100指数目前12个月远期市盈率为10.6,比世界其他地区低32%左右,而过去30年的平均折让率仅为10%。从绝对价值来看,它看起来也很便宜,其市盈率目前比30年平均水平14.0倍低约25%。
Schroders股票研究分析师Uzo Ekwue评论道:“相对于许多国际指数,英国股市的估值较低。中小市值公司的股价跌幅过大,更有可能从经济复苏中受益。”
Uzo Ekwue还说,富时100指数成分股的企业资产负债表上的现金水平很高,自由现金流收益率也很高,这应该会为股票回购和股息增加提供支撑。
作为股民,富时100指数哪些股票值得投资?
在经济动荡的情况下,对于普通股民来说,投资价格较低又稳定的富时100指数成分股似乎是个不错的选择。
但在谈到具体操作时,投资者们应该选择什么类型的股票呢?
Rathbone UK Opportunities基金经理Alexandra Jackson在接受《每日邮报》采访时表示,关注那些经济条件较好的家庭的消费领域是一个不错的投资思路。
他说:“虽然英国经济状况不佳,但还有一些有利因素。例如,美国消费者继续大手大脚地消费,而英国消费者的财务状况才刚刚开始有所恢复,他们在疫情封锁期间的数十亿积蓄并没有耗尽。此外,许多房贷借款人面临还款增加的问题,但好在一些固定利率产品的成本已低于4%。”
最后,英媒也根据Alexandra Jackson的推荐,总结了一部分可入手的股票,具体如下:
英国运动时尚零售商JD Sports制定了“三双”战略,目标是实现两位数的收入增长、两位数的市场份额和两位数的营业利润率。
得益于其在机场的门店,英国连锁便利店WH Smith正从逐渐恢复的度假热潮中蓬勃发展。
而在英国机场经营Ritazza、Upper Crust和其他咖啡馆的英国餐饮集团SSP Group正在拓展北美市场。
英国消费者保健和生命科学公司Croda International专门生产环保成分,用于越来越多的奢侈美容和护肤品牌,深受中产及以上人群的喜爱。
伦敦家具公司Howden Joinery为高端厨房用具提供原材料,适合那些想要改善而不是搬家的房主翻新厨房。
除了直接购买消费类成分股,英国基金和信托也是不错的投资对象,比如Rathbone UK Opportunities Fund和Murray Income,还有指数基金和交易所交易基金(ETF)。
例如,英国投资服务公司Bestinvest和Interactive Investor推荐的投资产品包括:
Artemis Income Fund基金
伦敦金融城信托( the City of London trust)
Lindsell Train UK Equity基金
Liontrust信托推出的UK Growth基金
Ninety One(晋达资产管理)推出的Alpha基金
值得推荐的还有Henderson Smaller Companies和Mercantile trusts信托,持有的中型和小型公司股价都低于其净资产价值。
英伦投资客写在最后
长期以来,英国股市过度依赖石油和矿业集团、银行、保险公司、公用事业和消费必需品,缺乏高增长科技股,一直维持在较低的市盈率。
这些特质在经济动荡之际反而从缺点变成了优点,这也成为富时100股指不断刷新历史纪录的原因,吸引不少投资者买入英国股市。
如果你正苦于如何进行投资和资产配置,希望今天的文章可以提供一些思路和启发。
免责声明:上述内容仅代表发帖人个人观点,不构成本平台的任何投资建议。